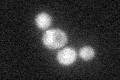
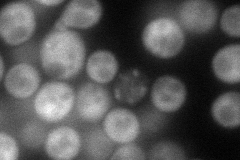
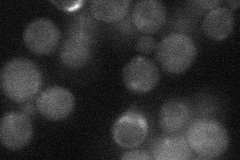
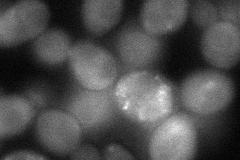

View description
Component of the RNA polymerase II holoenzyme, phosphorylated in response to oxidative stress; has a role in destruction of Ssn8p, which relieves repression of stress-response genes
Localization:
Intensity:
Fold change:
Significance:
-
C’ GFP library in SD
cytosol29.56 -
N' NOP1pr-GFP in SD
cytosol96.1833 -
N' TEF2pr-mCherry in SD

cytosol66.6971 -
N' NATIVEpr-GFP in SD
below threshold28.2413 -
N' TEF2pr-VC and Cyto-VN in SD
cytosol50.2091 -
C’ GFP library in SD+DTT

cytosol25.520.86No -
C’ GFP library in SD+H2O2

cytosol30.711.03No -
C’ GFP library in Starvation Media

cytosol29.430.99No -
C’ GFP library on the background of Pup2-DaMP

cytosol -
C’ GFP library on the background of CCT mutant

cytosol33.47981.13259No
